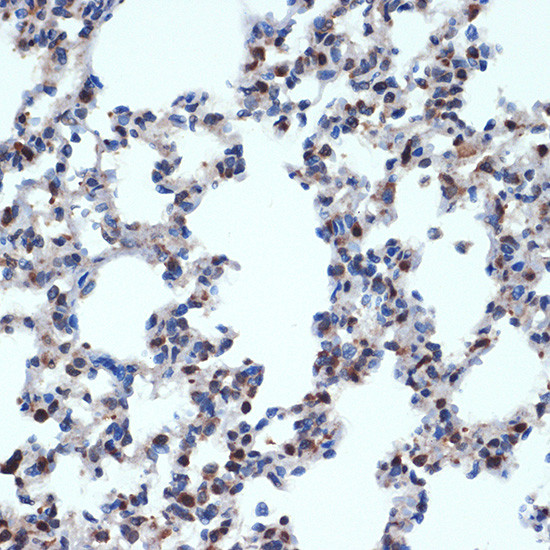
Gemin 2 Antibody in Immunohistochemistry (Paraffin) (IHC (P))

Search
Invitrogen
Gemin 2 Recombinant Rabbit Monoclonal Antibody (9C8K3)
{{$productOrderCtrl.translations['antibody.pdp.commerceCard.promotion.promotions']}}
{{$productOrderCtrl.translations['antibody.pdp.commerceCard.promotion.viewpromo']}}
{{$productOrderCtrl.translations['antibody.pdp.commerceCard.promotion.promocode']}}: {{promo.promoCode}} {{promo.promoTitle}} {{promo.promoDescription}}. {{$productOrderCtrl.translations['antibody.pdp.commerceCard.promotion.learnmore']}}
图: 1 / 3
Gemin 2 Antibody (MA5-37886) in IHC (P)



Please note: We are reviewing Western blot images included in the antibody testing data in our catalog, including those provided by third parties. Unless expressly labeled or annotated as “raw-unedited”, Western blot images included in the antibody testing data in our catalog may have been edited, optimized or otherwise adjusted for presentation.
产品信息
MA5-37886
种属反应
宿主/亚型
Expression System
分类
类型
克隆号
抗原
偶联物
形式
浓度
规格
纯化类型
保存液
内含物
保存条件
运输条件
RRID
产品详细信息
Positive Samples: U2OS, HeLa, MCF7, Mouse testis, Mouse thymus, Rat testis, Rat pancreas
Immunogen sequence: MRRAELAGLK TMAWVPAESA VEELMPRLLP VEPCDLTEGF DPSVPPRTPQ EYLRRVQIEA AQCPDVVVAQ IDPKKLKRKQ SVNISLSGCQ PAPEGYSPTL
靶标信息
SIP1 is one of the proteins found in the SMN complex, which consists of the survival of motor neuron (SMN) protein and several gemin proteins. The SMN complex is localized to a subnuclear compartment called gems (gemini of coiled bodies) and is required for assembly of spliceosomal snRNPs and for pre-mRNA splicing. SIP1 interacts directly with the SMN and it is required for formation of the SMN complex. A knockout mouse targeting the mouse homolog of this gene exhibited disrupted snRNP assembly and motor neuron degeneration. However, knockdown of the SIP1 mRNA in motor neurons showed normal motor axons while that of SMN mRNA did show abnormal motor axon outgrowth, indicating that SIP1 may have additional roles outside of the SMN complex.
仅用于科研。不用于诊断过程。未经明确授权不得转售。
篇参考文献 (0)
生物信息学
蛋白别名: Component of gems 2; Gem-associated protein 2; Gemin-2; SIP 1; SIP-1; SIP1 delta; SMN interacting protein-1; SMN-interacting protein 1; survival of motor neuron protein interacting protein 1; Survival of motor neuron protein-interacting protein 1; survivor of motor neuron protein interacting protein 1
基因别名: 1700012N19Rik; GEMIN2; SIP1
UniProt ID: (Rat) Q9QZP1, (Mouse) Q9CQQ4
Entrez Gene ID: (Rat) 84404, (Mouse) 66603